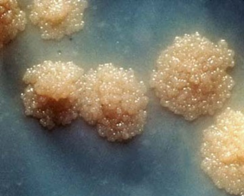

为全面加强结核病防治工作,国家卫生健康委、国家疾控局等部门于2024年11月底发布了《全国结核病防治规划(2024—2030年)》,指引各地区、各部门积极行动起来,携手终结结核病的流行,共同推动健康中国的建设。结核病是由结核分枝杆菌感染引起的一种慢性传染病,旧称“痨病”。据WHO报告显示,2023年全球结核病新发1 080万例,死亡125万例,成为传染病头号“杀手”。了解结核分枝杆菌的特点和传播途径,有助于制定有效的结核病预防措施。
一、结核分枝杆菌的主要特点
1882年3月24日,德国微生物学家Robert Koch发现结核分枝杆菌是引起结核病的病原体。结核分枝杆菌菌体细长,呈分枝生长的趋势,由于细胞壁中含有大量脂质,用抗酸染色法染色呈红色(图1)。结核分枝杆菌培养营养要求高,生长非常缓慢,大约20小时繁殖一代,需要3~4周才可在平板上形成疏水性、菜花样菌落(图2)。结核分枝杆菌对干燥、强酸碱抵抗力较强,而对75%乙醇、湿热、紫外线等抵抗力弱。结核分枝杆菌在宿主体内各种压力下,复制和代谢缓慢甚至停止,可形成持留菌或休眠菌,使机体处于潜伏结核感染状态。当压力消失,休眠菌可复苏引起结核病。目前全球约有1/4人口潜伏感染结核杆菌,其中5~10%的人会发展为结核病,是活动性结核病患者的重要来源。

图1 小鼠肺组织中的结核分枝杆菌抗酸染色(10×100倍)(图片来自本文作者)
图2 结核分枝杆菌菌落
二、结核分枝杆菌的传播途径
结核分枝杆菌很容易通过呼吸道传播,肺结核是最多、最常见的结核病临床类型,与肺结核患者共同居住,或同室工作、学习的人为肺结核患者的密切接触者,感染几率大。结核分枝杆菌还可通过消化道和伤口等感染人或动物。WHO报告显示,对中国结核病发病最大的5个危险因素依次是吸烟、饮酒、营养不良、糖尿病和HIV感染。机体感染结核分枝杆菌后,是否发展为结核患者,除了与细菌毒力和数量有关,与机体的免疫状况密切相关。免疫力低下人群为结核病高危人群,如艾滋病患者、糖尿病患者、免疫抑制剂使用者、尘肺患者和老年人等。
三、结核分枝杆菌感染的主要症状
结核分枝杆菌主要受累器官为肺脏。肺结核患者症状主要有持续的咳嗽,咳痰,痰中可带血丝,严重者可能出现咯血、胸痛等症状。患者一般有持续低热,午后比较明显,常用退烧措施效果不明显。有些可出现熟睡后大汗淋漓、湿透衣服的现象,称为“盗汗”。患者常常容易疲倦,还伴有食欲减退、体重下降等全身症状。除了毛发、牙齿和指甲外,结核分枝杆菌可侵犯人体几乎所有组织器官而引起相应的临床症状,导致骨结核、肠结核、淋巴结核和肾结核等疾病。结核潜伏感染者具有对结核分枝杆菌的免疫反应,但是没有细菌学或临床影像学证据,也不具有传染性,绝大多数不需要治疗。
四、结核病的治疗及疫苗
药物治疗是结核病治疗的核心,其他治疗包括对症治疗、手术治疗和中药等。早期、联合、足量、规律、全程是结核病药物治疗的基本原则。WHO推荐使用的督导短程化疗(DOTS)策略能够治愈90%以上的患者。肺结核药物治疗全程为6-8个月,但是肺结核患者如果不规范治疗,容易产生耐药肺结核,则治疗全程长达18-24个月,且治愈率低,治疗费用高。因此,结核病患者要谨遵医嘱,规律用药,万万不可自行停药,并在用药期间定期复诊。卡介苗是目前唯一被批准的结核病预防用疫苗。广泛接种卡介苗能大大地降低结核病的发病率。WHO推荐结核病高负担国家应将卡介苗接种作为儿童计划免疫规划的一部分。我国规定新生儿出生后立即皮内接种卡介苗,即“出生第一针”。
五、预防结核病传播的一般措施
1. 养成良好的卫生习惯,咳嗽时用纸巾捂住口鼻,不随地吐痰。
2.与人交谈,尤其是有咳嗽等呼吸道感染症状者,要保持合理的距离。
3.合理饮食,保证充足的睡眠,锻炼身体,以提高身体抵抗力。
4.去人多、空气不好的地方,以及医院、肺结核科门诊等感染高危地区,建议佩戴医用口罩。
5.人口比较密集的环境中,如学校、幼儿园、医院等应当保持通风,必要时放置紫外光仪器空气消毒。
6.对结核病密切接触者和高风险人群进行结核潜伏感染筛查,必要时进行预防性抗结核治疗。
作者简介:柏银兰,空军军医大学基础医学院副教授、军事医学创新中心研究员,陕西省微生物学会常务理事,中国微生物学会医学微生物与免疫学专业委员会副主任委员,中国防痨协会人兽共患病结核病专业分会常务委员
来源: 陕西省微生物学会
科普中国公众号
科普中国微博

帮助
中国微生物学会